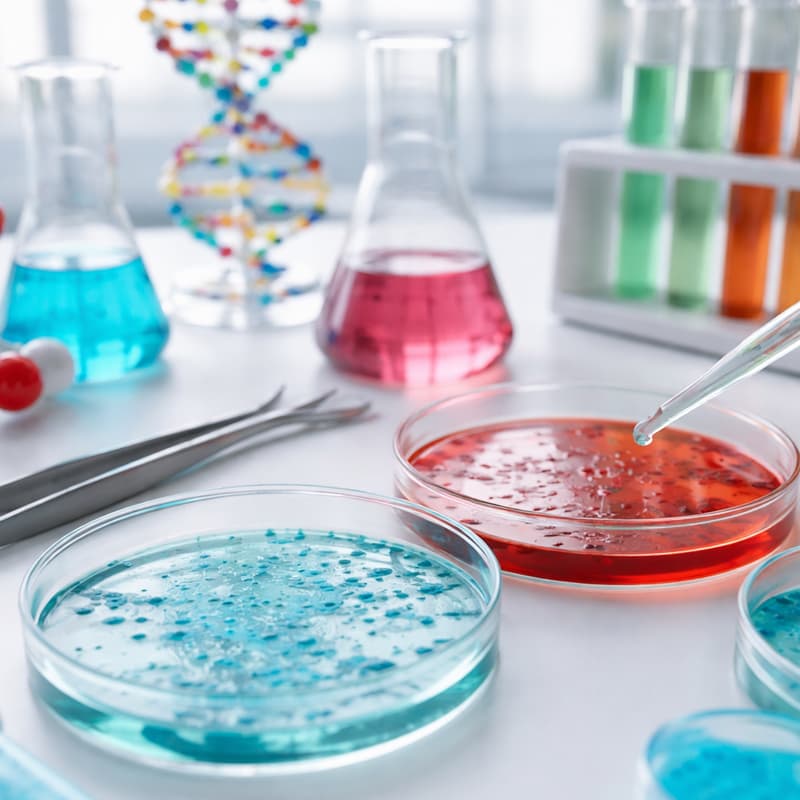
Cover Image for EAS Lunch #5 - Mirror Biology

EAS Lunch #5 - Mirror Biology
Come to EA Sweden lunches! Bring your own food and join us for a short 15-minute talk designed to spark thoughtful conversations about impact and doing good.
Drop-in: 12-12:10
Presentation starts: 12:15
🎤 Speaker: Chris Stamper
Chris will introduce the concept of Mirror Biology, a potential biosecurity concern related to creating biological systems that are chemically “mirrored” versions of life as we know it. While this area of research could open new scientific possibilities, it also raises important questions about safety and global biosecurity.
In this session, Chris will explain what mirror biology is, what risks researchers are currently discussing, and what efforts are underway to reduce potential dangers. He will also share his own path into biosecurity and how he transitioned into working on these issues.
You can stay and co-work with us afterwards too...the more the merrier!